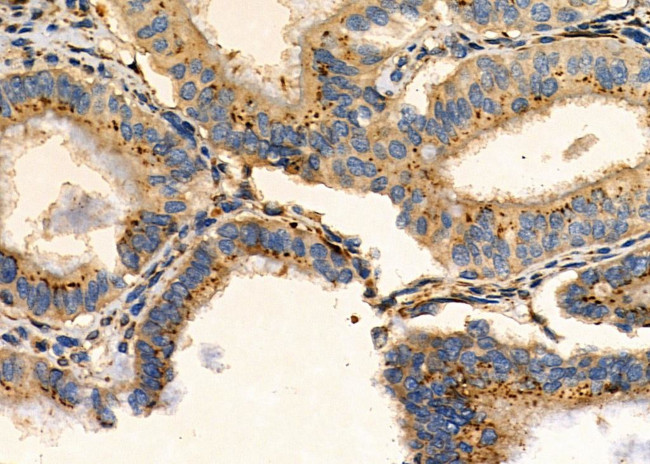
GABRG1 Antibody in Immunohistochemistry (Paraffin) (IHC (P))

Search
Invitrogen
GABRG1 Polyclonal Antibody
{{$productOrderCtrl.translations['antibody.pdp.commerceCard.promotion.promotions']}}
{{$productOrderCtrl.translations['antibody.pdp.commerceCard.promotion.viewpromo']}}
{{$productOrderCtrl.translations['antibody.pdp.commerceCard.promotion.promocode']}}: {{promo.promoCode}} {{promo.promoTitle}} {{promo.promoDescription}}. {{$productOrderCtrl.translations['antibody.pdp.commerceCard.promotion.learnmore']}}
图: 1 / 2
GABRG1 Antibody (PA5-99317) in IHC (P)


Please note: We are reviewing Western blot images included in the antibody testing data in our catalog, including those provided by third parties. Unless expressly labeled or annotated as “raw-unedited”, Western blot images included in the antibody testing data in our catalog may have been edited, optimized or otherwise adjusted for presentation.
产品信息
PA5-99317
种属反应
已发表种属
宿主/亚型
分类
类型
抗原
偶联物
形式
浓度
规格
纯化类型
保存液
内含物
保存条件
运输条件
RRID
产品详细信息
Antibody detects endogenous levels of GABRG1.
靶标信息
Gabrg1 encodes a protein that belongs to the ligand-gated ionic channel family. Gabrg1 is an integral membrane protein and plays an important role in inhibiting neurotransmission by binding to the benzodiazepine receptor and opening an integral chloride channel. The Gabrg1 gene is clustered with three other family members on chromosome 4. GABAA receptors are members of the Cys-loop family of ligand-gated ion channels and, along with GABAB receptors, are responsible for mediating the inhibitory effects of GABA. Structurally, Gabrg1 are pentameric proteins, consisting of five subunits belonging to different families. Diseases associated with GABRG1 include Alcohol Dependence.
仅用于科研。不用于诊断过程。未经明确授权不得转售。
生物信息学
蛋白别名: GABA(A) receptor subunit gamma-1; GABAAR gamma1; GABAAR subunit gamma-1; Gabeg1; gamma-aminobutyric acid; gamma-aminobutyric acid (GABA-A) receptor, subunit gamma 1; gamma-aminobutyric acid A receptor, gamma 1; Gamma-aminobutyric acid receptor subunit gamma-1
基因别名: GabaA; GabaA/BZ; GABRG1
UniProt ID: (Rat) P23574, (Mouse) Q9R0Y8
Entrez Gene ID: (Rat) 140674, (Mouse) 14405